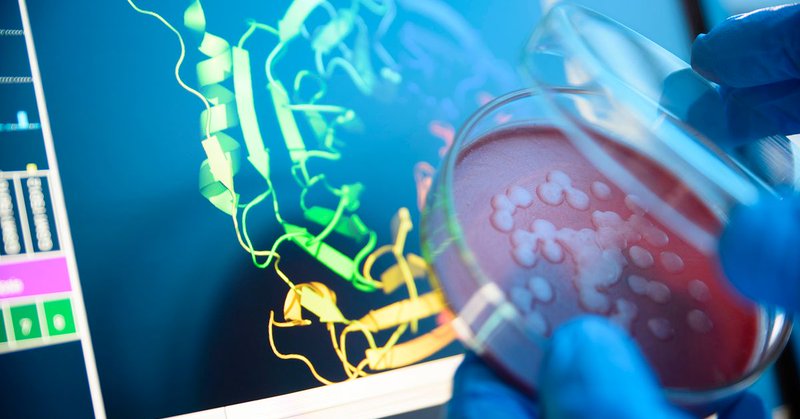

Wellcome-Wolfson Institute Experimental Medicine
@WWIEM_QUB
Followers
1K
Following
1K
Media
124
Statuses
672
Wellcome-Wolfson Institute for Experimental Medicine. Queen's University Belfast. Understanding mechanisms of disease to improve patient outcomes.
Belfast, Northern Ireland
Joined October 2018
Joins us tomorrow for the 2025 Barcroft Medal Lecture by Prof Barbara Casadei "Atrial fibrillation and stroke: a multidisciplinary look at an old problem" 🗓️Wednesday 15th October 3 PM 🏛️MBC Lecture Theatre 1
0
1
1
The 2026 UK CellularMicrobiologyNetwork meeting will be held 22nd - 23rd of June at @WWIEM_QUB in Belfast. Researchers from the UK and beyond are invited to share exciting work on the mechanisms of host-pathogen interactions. Follow us to stay tuned! https://t.co/XVnqr0bGaj
0
2
5
A major new clinical trial, led by our experts, has shown that mucus-thinning drugs are ineffective in people with bronchiectasis. The CLEAR trial looked at 288 adults with non-cystic fibrosis bronchiectasis across the UK for over 52 weeks to determine the clinical and cost
1
6
6
Fantastic to be part of this really important #clinicaltrial in #bronchiectasis, led by @JudyBradley2910 Very proud that we contributed lots of participants. @NICRNCoordCentr @QUBelfast @WWIEM_QUB @NICRFqub
Original Article: Hypertonic Saline or Carbocisteine in Bronchiectasis (CLEAR trial) https://t.co/FleRvkTPUf Editorial: Time to Reconsider Mucoactive Agents for Airway Clearance https://t.co/r5hozIXKw9
#ERSCongress | @EuroRespSoc
1
2
11
We enjoyed so much working with @W5Belfast Belfast and @QUBelfast 's SARC in developing this immersive exhibition! Step Inside: The World of Antimicrobial Resistance We can't wait to see how you like it! @QUBstaff
@MHLSQUB
@QUBAlumni
💡 Ever wondered how medicines work and what happens when they don’t? 🤔 Running daily until 15 September, W5 is hosting Step Inside: The World of Antimicrobial Resistance, a brand-new immersive exhibition created with @QUBelfast. Perfect for curious kids (and parents too!),
0
2
2
RESEARCH BREAKTHROUGH: Discovery could lead to new drug treatments for #InflammatoryDiseases including #Alzheimers, #asthma, #arthritis and #obesity. Find out more: https://t.co/OzngM61qCK
#LoveQUBResearch @WWIEM_QUB @bioagelabs @MHLSQUB
1
10
27
And now it's live!!!!! Visit this immersive experience on the global threat of antimicrobial resistant infections, and our research at @wwiem_qub @QUBelfast to fight it. Where: W5 (1st Floor) 2 Queens Quay Belfast When: 1st-15th Sep
0
4
12
0
0
4
Step inside an immersive experience to learn about the global threat of antimicrobial resistant infections, how bacteria develop resistance to antibiotics and the research from @wwiem_qub at @QUBelfast to fight it. Where: W5 (1st Floor) 2 Queens Quay Belfast When: 1st-15th Sep
0
2
6
Congratulations to Prof Frank Cassey on receiving the 2025 Newburger-Bellinger Cardiac Neurodevelopmental Award from the Cardiac Neurodevelopmental Outcome Collaborative. He is the first recipient from the UK & IE to receive it. https://t.co/yMghHT6Hkj
@MHLSQUB
@QUBstaff
cardiacneuro.org
The Cardiac Neurodevelopmental Outcome Collaborative is a not-for-profit organization established to determine and implement best practices of neurodevelopmental and psychosocial services for...
0
2
8
🚨 Last chance to apply - Strategic Management & Leadership in Primary Care Short Course! 🚨 ✅ Fully Funded places available ✅ Build leadership skills to drive change in healthcare ✅ Workshops spaced over the year to suit busy schedules 📲 Apply now: https://t.co/AEydnrbvpr
0
0
0
I have been asked many times why I moved from USA to @QUBelfast. @ScholarGPS officially ranked QUB 1st for lifetime research in #DiabeticRetinopathy #DiabeticRetinalDisease and it wasn’t a better fit for me to start my laboratory as a new investigator @Diabetescouk @The_MRC
1
3
10
🎉 Huge Congratulations to the UIG Prize 2025 Winners!🏆#UIGPrize2025 A massive well done to Georgia Miles (Queen's University Belfast) and Sarah Hughes (Ulster University) — awarded as the top two undergraduate students in #Immunology across #NorthernIreland! 👩🔬🧫 @britsocimm
0
2
9
We are delighted to share that @valvanolab 's @BBSRC research has been featured in its impact showcase. This showcase celebrates BBSRC's 30 anniversary - a three-decade journey driven by commitment, collaboration and innovation. https://t.co/9OGbNW8BoX
discover.ukri.org
For three decades, the Biotechnology and Biological Sciences Research Council (BBSRC) has supported and enabled cutting-edge bioscience research and innovation that has helped improve lives and...
0
0
3
Congratulations to the team at COMBAT clinical trial on the first site opening and patient recruitment this week! Combat is a randomised equivalence clinical on the management of rhegmatogenous retinal detachment led by Prof Noemi Lois. @NIHRresearch
https://t.co/SgKFsDw2EX
0
1
1
We just launched a research hub to tackling #MultipleSclerosis The NI MS Research Hub will bring together a collaborative team of experts to help accelerate leading research and improve the lives of people affected by the condition https://t.co/1C8fZrkd23
@QUBelfast @mssocietyNI
0
10
15
Transforming MS Research in Northern Ireland and globally! Our launch event will take place in the Great Hall of the Lanyon Building at Queen’s University Belfast today! Full information: https://t.co/ruqfRJcUbu
#MSResearch #ms #multiplesclerosis #multiplesclerosisawar
2
4
12
Congratulations to ReproGO, Start Up from @WWIEM_QUB! ReproGo, named finalist at the Northern Ireland StartUp Awards 2025: 1. Medtech & Healthtech StartUp of the Year 2. Equity-Backed StartUp of the Year Looking forward to the finals in June! https://t.co/MzE1ob95jN
#UKSUA
0
1
6
Huge congratulations to @rodgers_aoife, Lecturer at @WWIEM_QUB on her @acmedsci Springboard Award. #Springboard25
@QUBelfast @MHLSQUB @QUBAlumni
📢 We're making our largest ever investment in early-career researchers Through #Springboard25, we’re investing £7.6m in 62 researchers to drive innovations that improve health and wellbeing 🌍🔬 Congrats to all 2025 awardees! 🎉 👉 https://t.co/0yQsj28C8o
@SciTechgovuk
4
3
18